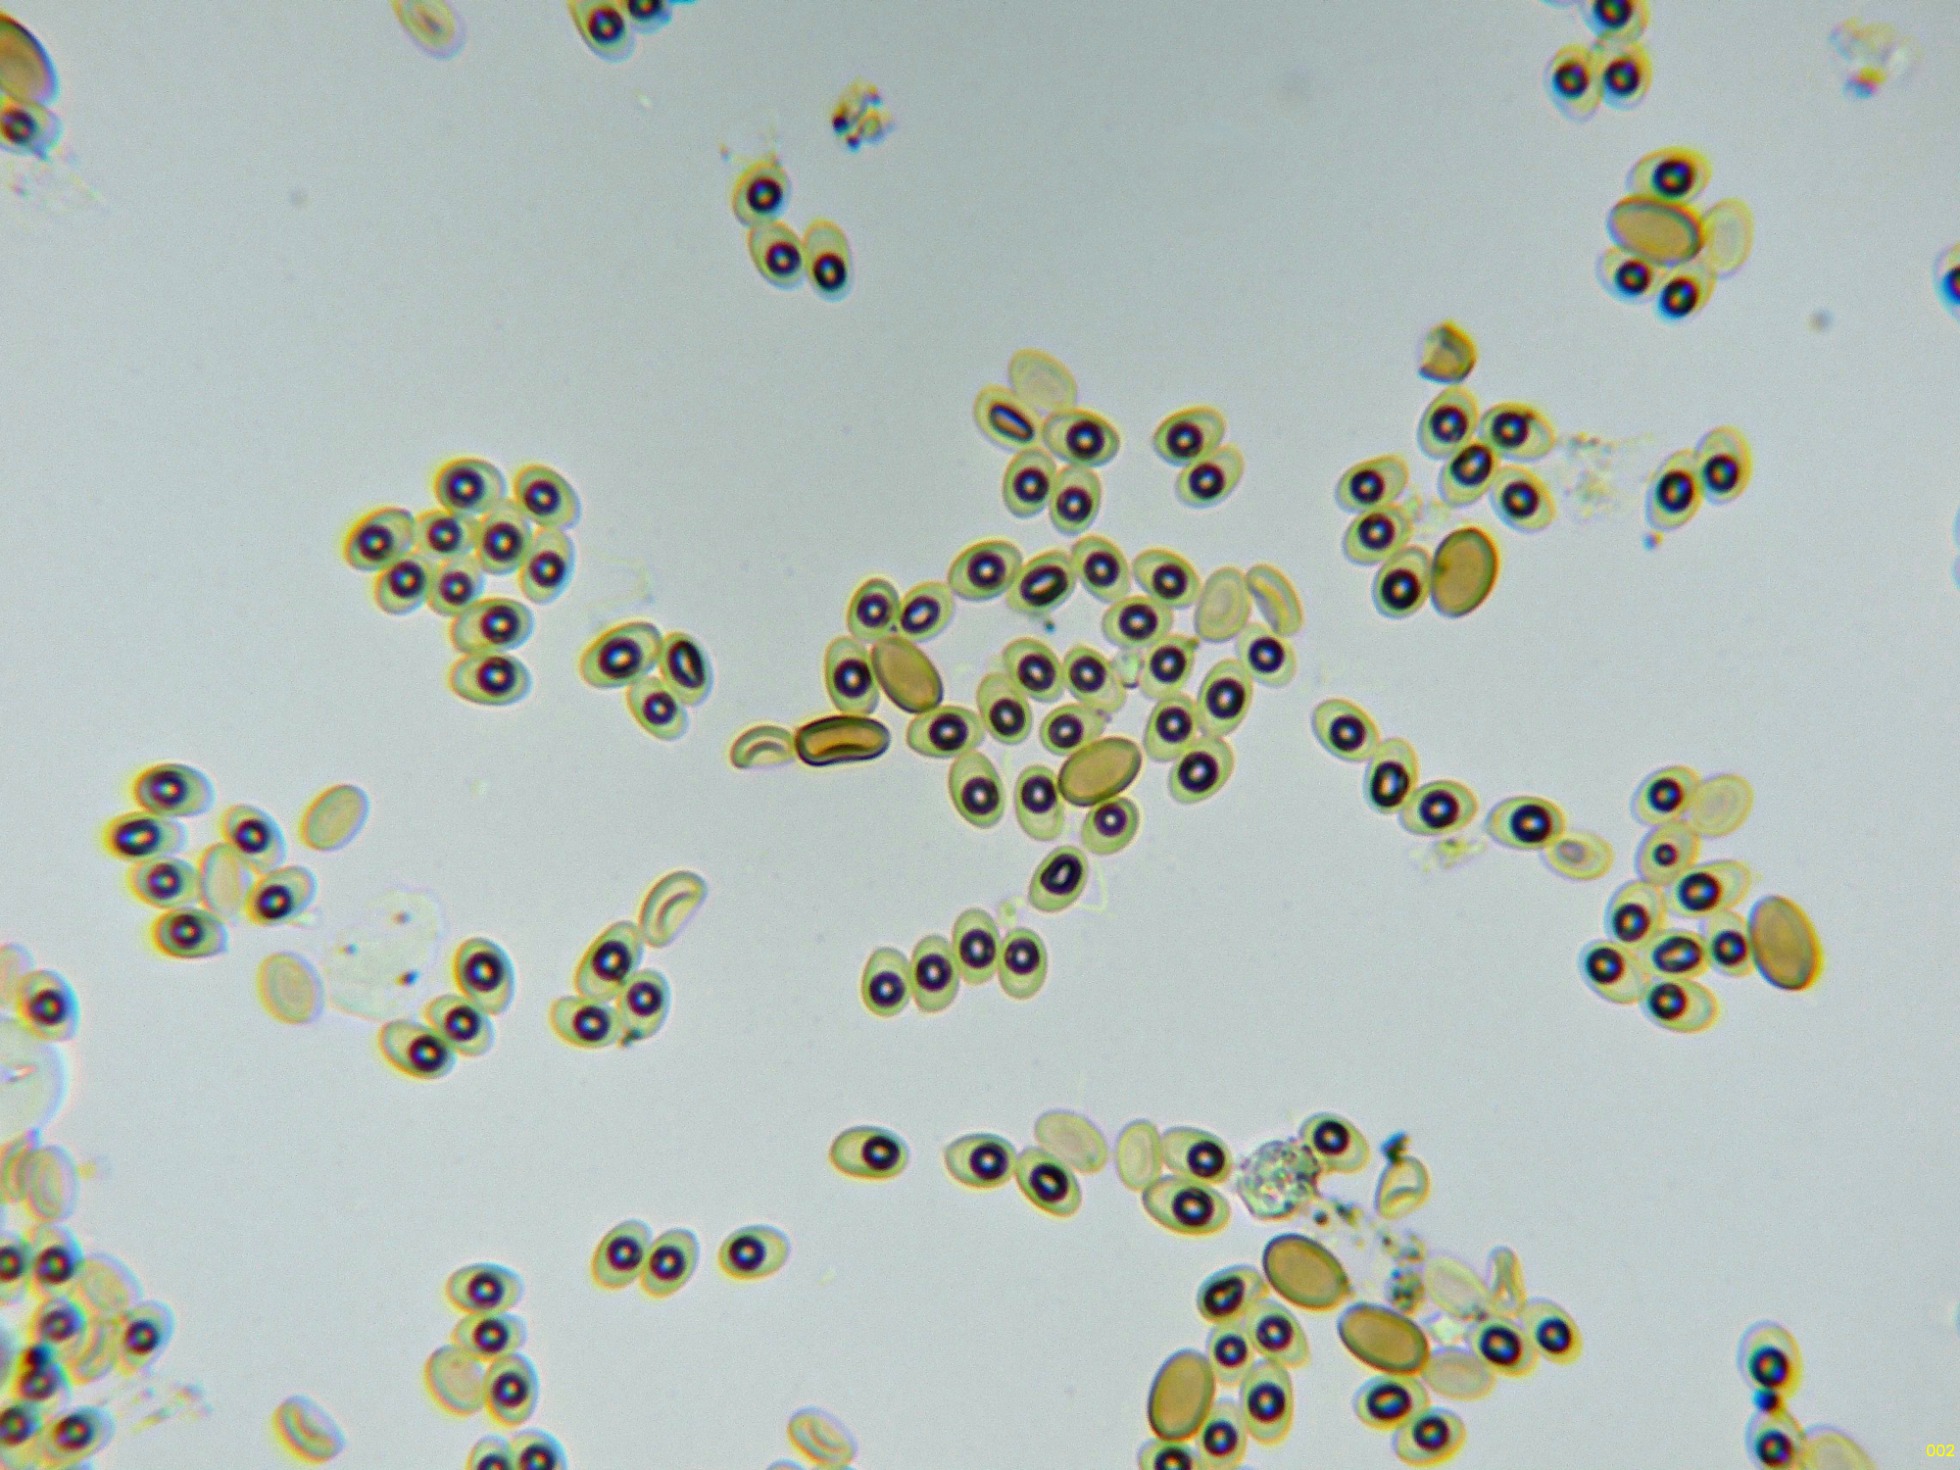
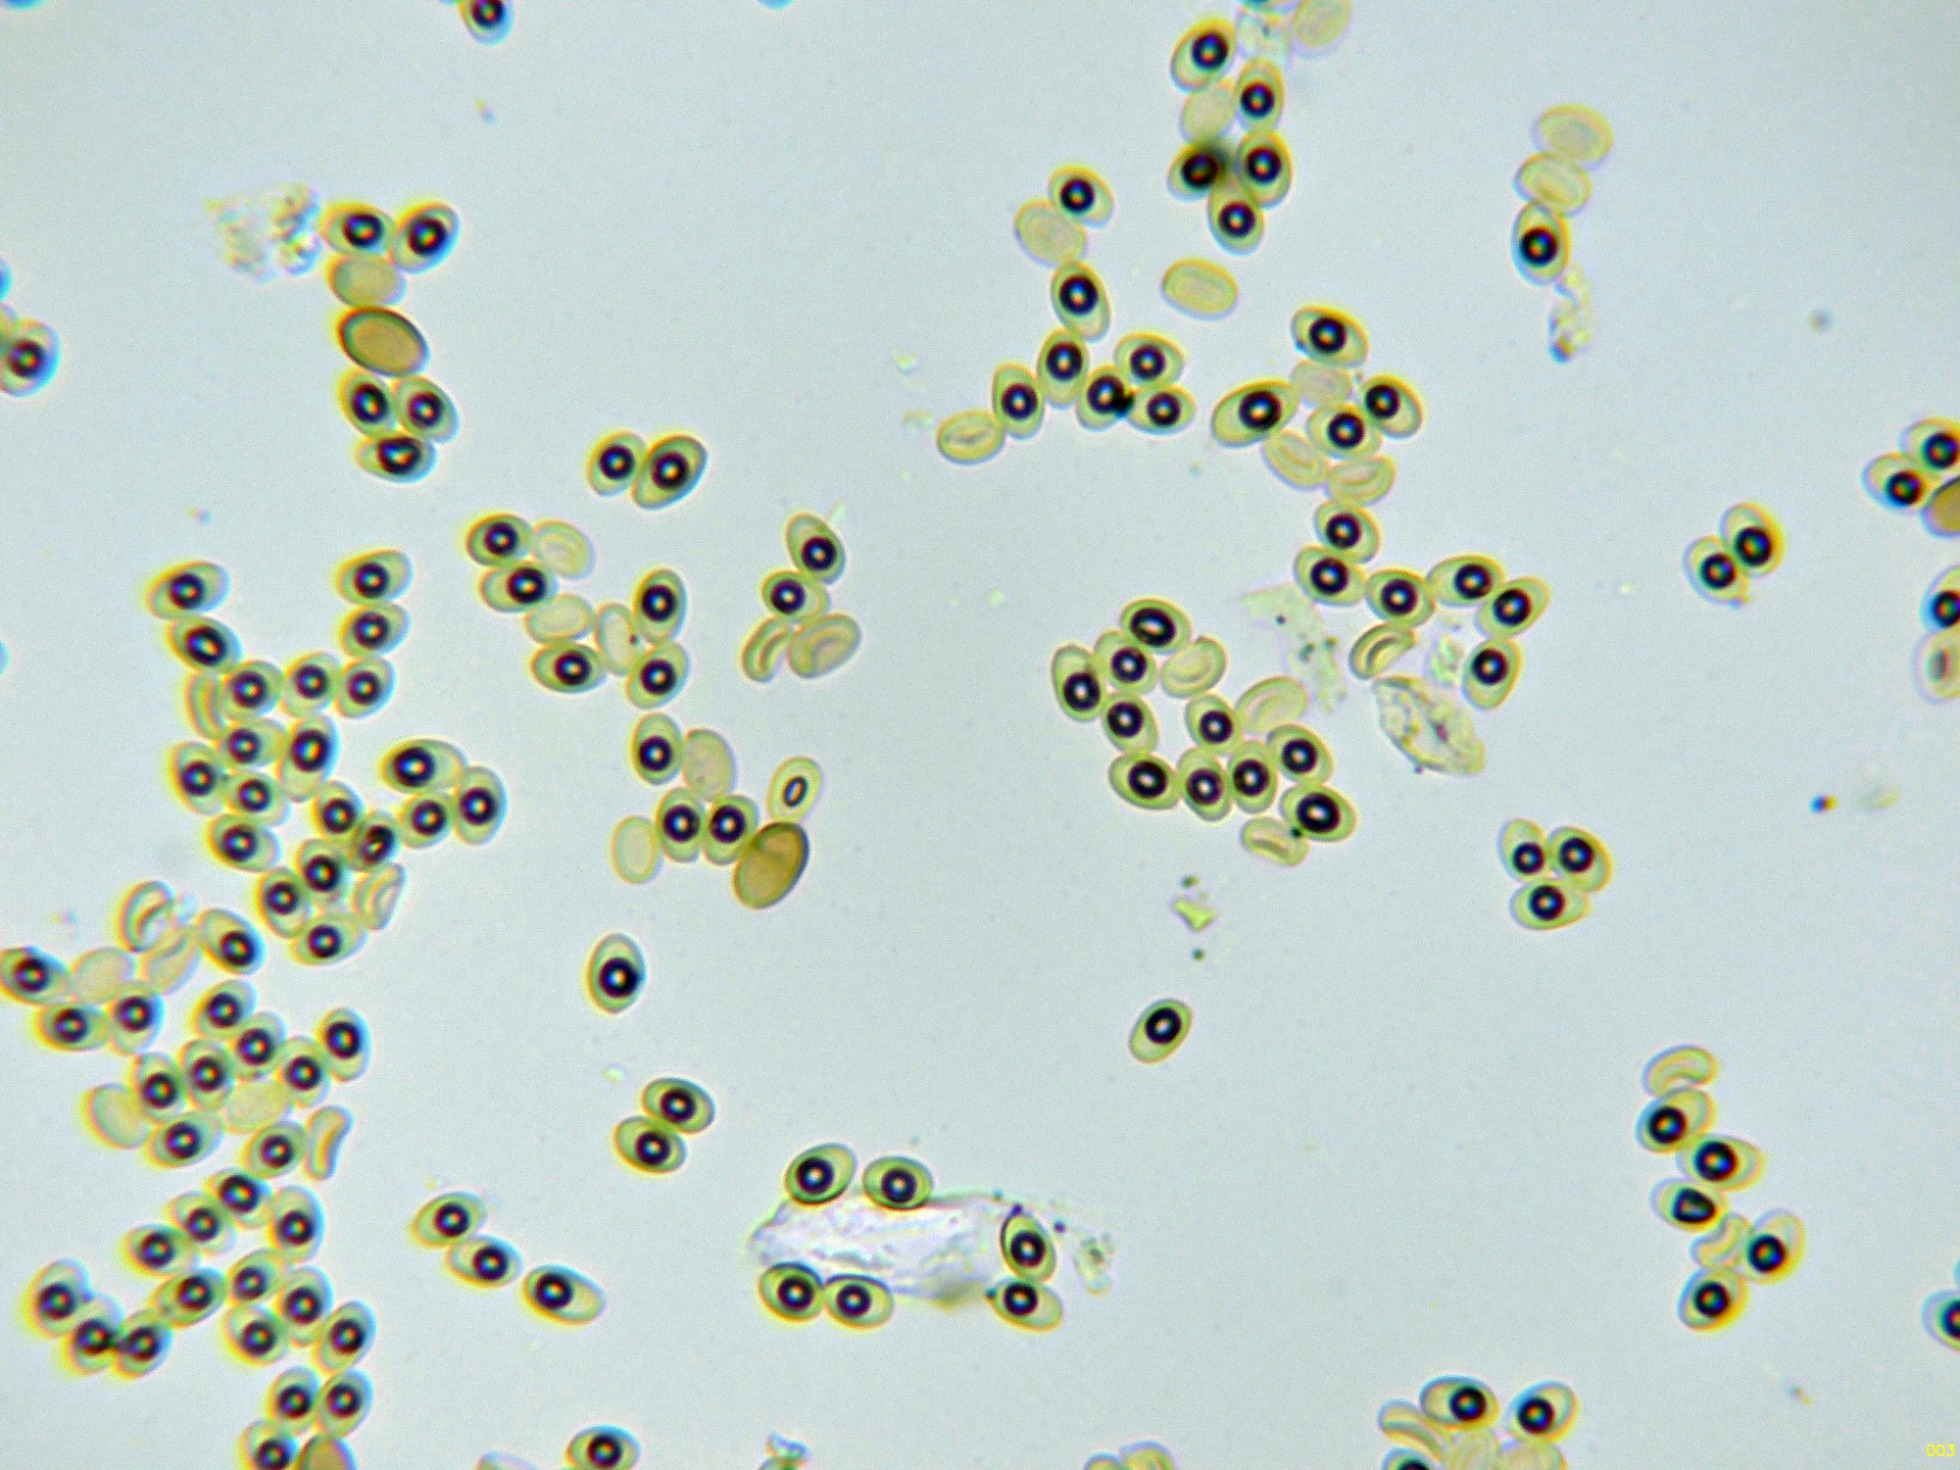
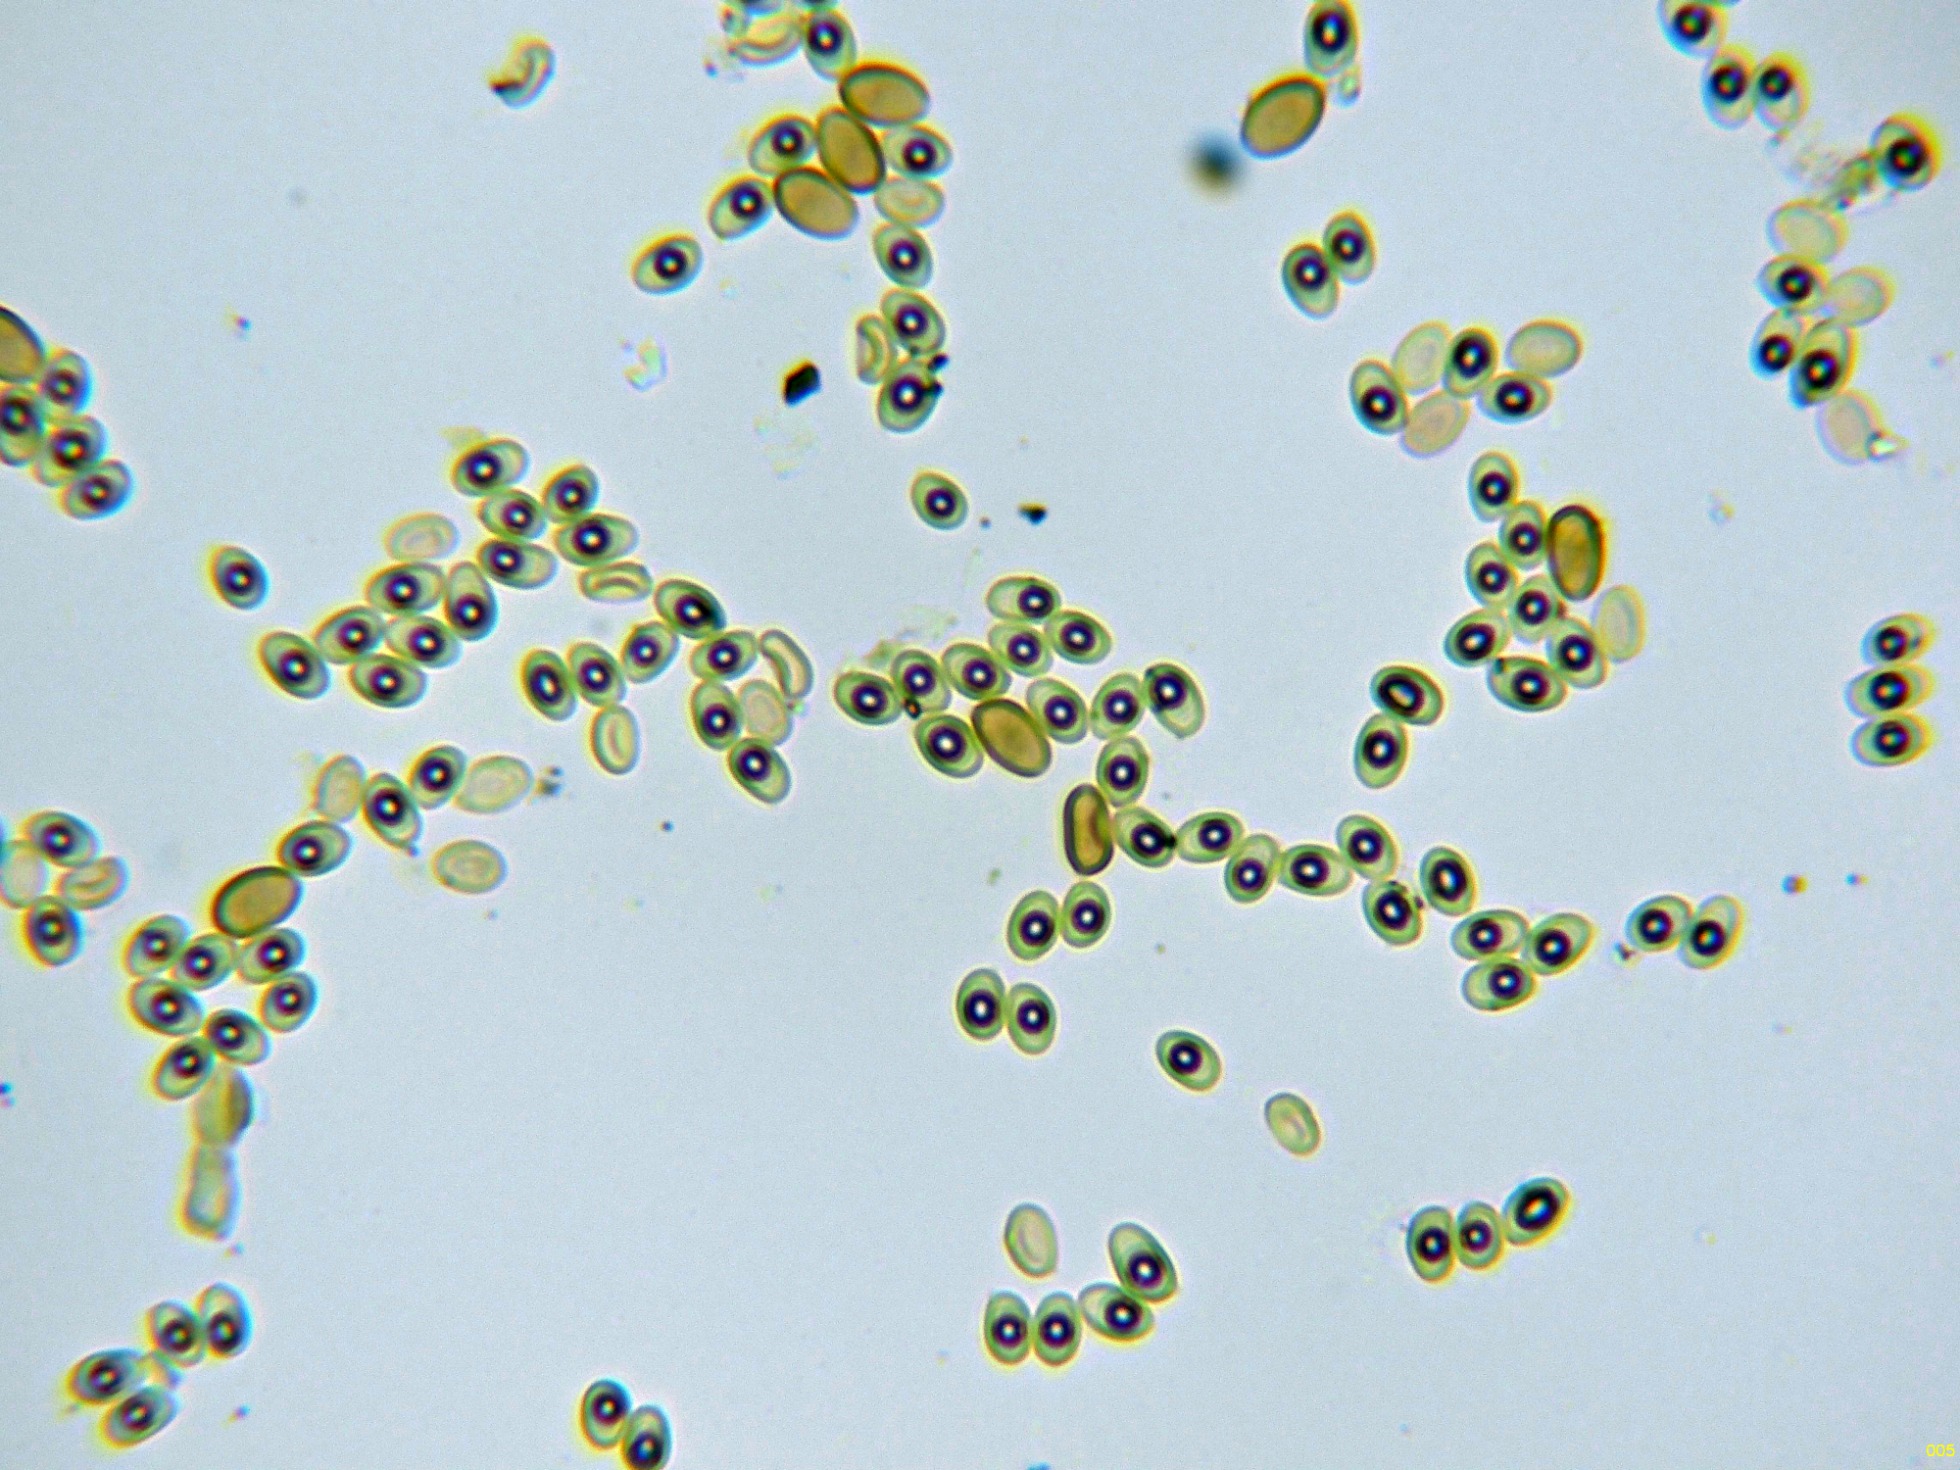

- Foro
- Foros sobre Micología de fungipedia
- Microscopía
- Antrodia: Cuando los datos no se corresponden con la realidad.
 Antrodia: Cuando los datos no se corresponden con la realidad.
Antrodia: Cuando los datos no se corresponden con la realidad.
- Josep Torres
-
 Autor del tema
Autor del tema
- Fuera de línea
- Moderador
-

Menos
Más
- Mensajes: 8746
- Gracias recibidas: 8379
8 meses 4 semanas antes - 8 meses 4 semanas antes #110586
por Josep Torres
Hola.
Una Antrodia fotografiada el 6 de diciembre del pasado año, brotando sobre la superficie de un tronco completamente carbonizado de pino.
A tenor de la microscopía obtenida, no pude llegar a ninguna conclusión medianamente convincente, por lo que opté como de costumbre por el análisis molecular, la secuenciación del gen ITS no dejó lugar a dudas dando una coincidencia del 100% con la Antrodia sinuosa, como la microscopía obtenida no se correspondía para nada con lo que entiendo como Antrodia sinuosa, y dando por seguro que el resultado se debería a una contaminación, mandé de nuevo nuevas muestras, simplemente fue tirar el dinero, con el resultado idéntico de 100% Antrodia sinuosa.
Vamos con las imágenes:
Superficie poroide a 20 aumentos, con 4 a 5 poros por mm., con poros de pared gruesa, con el borde liso, no dentado.
Hifas subiculares en solución de Rojo Congo:
Hifas subiculares en solución de KOH:
Basidios de muy difícil observación, unos pocos de estos basidios en solución de Rojo Congo diluido:
Y lo que se supone esporas, estas esporas obtenidas por esporulación natural y en agua:
En las imágenes se pueden observar dos clases de esporas distintas, por un lado unas esporas muy numerosas, entre ovoides y elipsoides, de pared fina, con una gran gota lípida en su interior y con unas medidas en agua de:
(5.1) 5.2 - 5.7 (6) × (2.9) 3.3 - 3.8 (4) µm
Q = (1.4) 1.44 - 1.6 (1.8) ; N = 40
Me = 5.5 × 3.6 µm ; Qe = 1.5
Luego tenemos otras esporas estas menos numerosas, de pared gruesa, lisas, con pigmento marrón pardo claro en su interior y unas medidas en agua de:
(6.2) 6.5 - 7.1 (7.3) × (3.5) 3.8 - 4.5 (4.7) µm
Q = (1.4) 1.5 - 1.8 (1.9) ; N = 20
Me = 6.7 × 4.2 µm ; Qe = 1.6
Medidas ligeramente por encima de las anteriores.
Este mismo día y en un troco cercano al anterior, me encuentro con lo que parece tratarse de lo mismo:
La superficie poroide a 20 aumentos:
Hifas subiculares en solución de Rojo Congo:
Las hifas subiculares en Reactivo de Melzer:
Las mismas en solución de KOH:
En este estudio los basidiomas ya estaban bastante resecos y soltaron pocas esporas por medio de la esporulación natural, añado una imágen:
Aunque son pocas las esporas obtenidas, atendiendo a su morfología personalmente no me cabe duda de que en ambos estudios se trata de lo mismo.
Vamos con el árbol filogenético:
Aquí mi especie la "Antrodia JTP 2468/24", se encuentra perfectamente alineada dentro del Clado de lo que podemos considerar como Antrodia sinuosa = Amyloporia sinuosa = Adustoporia sinuosa.
La especie aquí descrita atendiendo a sus características, no se corresponde para nada con la descripción que hace Ryvarden de la Antrodia sinuosa en su trabajo de 2017, dejo la descripción de la especie:Antrodia sinuosa.
Sysr. Mycol. 1: 381, 1821.
"Basidiocarpos anuales, resupinados y a menudo ampliamente efusivos, ásperos y duros en seco, de hasta 3 mm de grosor, separables, raramente resinosos y abigarrados, margen blanco, fimbriado, estrecho o casi inexistente; superficie de los poros de color blanco marfil o madera o marrón sórdido pálido al secarse, poros angulares o sinuosos, de 1 a 3 (4) por mm, diseptimentos enteros a dentados, que al secarse suelen agrietarse y partirse en configuraciones semilaberínticas; subículo algodonoso-áspero, blanco, de aproximadamente 1 mm de grosor; capa tubular del mismo color que el subículo, de hasta 5 mm de grosor. Sistema hifal dimítico; hifas generativas fibuladas, de paredes gruesas, hialinas, de 2-4,5 μm de diámetro; hifas esqueléticas hialinas, de paredes gruesas o semisólidas, sinuosas a rectas, ocasionalmente ramificadas, de 2-5 μm de diámetro, más comunes en el subículo que en el tronco.
No hay cistidios, pero los cistidiolos fusoides no salientes suelen estar presentes entre los basidios, de 1,2-20 x 3-4 μm.
Basidios: de 11 a 15 x 4-5 μm, clavados.
Basidiosporas: de 4-6 (-7) x 1-2 μm, cilíndricas a subalantoides.
Sustratos: Madera muerta de coníferas como Abies, Larix, Picea y Pinus, a menudo sobre troncos quemados, y más raramente sobre maderas duras como Betula y Fraxinus.
Distribución: Común y circumpolar en la zona boreal de coníferas; en Europa, siguiendo a las coníferas dondequiera que crezcan de forma natural, o bien extendida en Norteamérica, Asia Oriental y el norte de África (Marruecos).
Observaciones: La especie suele ser fácil de reconocer en el campo debido a sus poros irregulares, a menudo con disepimentos dentados, y a su color marrón pálido sórdido al secarse."
De todo lo descrito solo encaja que según Ryvarden aparece a menudo sobre troncos quemados, no encajan los poros más pequeños y aunque angulares, ninguno agrietado y ni mucho menos semilaberíntico, y sobre todo no encajan para nada las medidas esporales según Ryvarden de 4-6 (-7) x 1-2 μm. y en mi estudio de (5.1) 5.2 - 5.7 (6) × (2.9) 3.3 - 3.8 (4) µm., unas medidas con una anchura estratosféricamente por encima.
Para poder comparar, añado unas imágenes correspondientes a 4 estudios míos anteriores realizados a lo que en su momento y atendiendo al criterio de Ryvarden, consideré como Antrodia sinuosa, todas recolectadas sobre madera de pino.
La primera imágen es de un estudio del 9 de noviembre de 2019:
En este estudio las esporas midieron:
(4.2) 4.6 - 5.5 (5.7) × (1.2) 1.4 - 1.65 (1.7) µm
Q = (2.7) 2.9 - 3.7 (4.2) ; N = 30
Me = 4.9 × 1.5 µm ; Qe = 3.3
Otra imágen esta es del 2 de abril de 2021:
Sus esporas con unas medidas de:
(4) 4.4 - 5.3 (6.1) × (1.2) 1.4 - 1.8 (2) µm
Q = (2.3) 2.6 - 3.4 (3.8) ; N = 40
Me = 4.9 × 1.6 µm ; Qe = 3
Seguimos con otro estudio realizado el 26 de mayo de 2024:
En este caso sus esporas arrojaron unas medidas de:
(4.3) 4.6 - 5.6 (6.2) × (1.4) 1.6 - 1.9 (2) µm
Q = (2.4) 2.7 - 3.3 (3.8) ; N = 27
Me = 5.1 × 1.8 µm ; Qe = 2.9
Y para terminar un estudio realizado el 15 de septiembre de 2024:
Sus esporas con unas medidas de:
(5) 5.2 - 5.7 (5.8) × (1.4) 1.44 - 1.7 (1.8) µm
Q = (3.1) 3.3 - 4 (4.1) ; N = 30
Me = 5.5 × 1.5 µm ; Qe = 3.6
En todos mis anteriores estudios, las medidas esporales encajan a la perfección con las indicadas por Ryvarden, así como los poros de mayor tamaño, con el borde dentado y hasta incluso laberínticos.
Conclusión: Si tal y como parece indicar en base a los datos moleculares debo aceptar que en este caso al igual que en mis estudios anteriores estamos ante la Antrodia sinuosa, la única explicación plausible, aunque Ryvarden no lo cita en su artículo, sería que lo que he considerado como esporas, no se trataría de basidiosporas sinó de clamidosporas, que procederían directamente de las hifas subhimeniales, no de los basidios, de todos modos tampoco me explico como estas aparentes clamidosporas, pueden presentar dos morfologías distintas.
No es la primera vez que me sucede algo parecido, cuatro años atrás y después de repetir por 2 veces el análisis molecular, sigo sin estar conforme con el resultado, dejo el enlace:
www.fungipedia.org/setas-informacion-y-c...or-buena.html#106963
A día de hoy sigo sin ver la Trametes versicolor por ningún lado, aunque el árbol filogenético no parece dejar lugar a dudas
Mi Trametes, la Trametes 1505137_32645_1B_ITS4B, queda perfectamente alineada dentro de lo que debemos considerar como Trametes versicolor.
Saludos.
Una Antrodia fotografiada el 6 de diciembre del pasado año, brotando sobre la superficie de un tronco completamente carbonizado de pino.
A tenor de la microscopía obtenida, no pude llegar a ninguna conclusión medianamente convincente, por lo que opté como de costumbre por el análisis molecular, la secuenciación del gen ITS no dejó lugar a dudas dando una coincidencia del 100% con la Antrodia sinuosa, como la microscopía obtenida no se correspondía para nada con lo que entiendo como Antrodia sinuosa, y dando por seguro que el resultado se debería a una contaminación, mandé de nuevo nuevas muestras, simplemente fue tirar el dinero, con el resultado idéntico de 100% Antrodia sinuosa.
Vamos con las imágenes:
Superficie poroide a 20 aumentos, con 4 a 5 poros por mm., con poros de pared gruesa, con el borde liso, no dentado.
Hifas subiculares en solución de Rojo Congo:
Hifas subiculares en solución de KOH:
Basidios de muy difícil observación, unos pocos de estos basidios en solución de Rojo Congo diluido:
Y lo que se supone esporas, estas esporas obtenidas por esporulación natural y en agua:
En las imágenes se pueden observar dos clases de esporas distintas, por un lado unas esporas muy numerosas, entre ovoides y elipsoides, de pared fina, con una gran gota lípida en su interior y con unas medidas en agua de:
(5.1) 5.2 - 5.7 (6) × (2.9) 3.3 - 3.8 (4) µm
Q = (1.4) 1.44 - 1.6 (1.8) ; N = 40
Me = 5.5 × 3.6 µm ; Qe = 1.5
Luego tenemos otras esporas estas menos numerosas, de pared gruesa, lisas, con pigmento marrón pardo claro en su interior y unas medidas en agua de:
(6.2) 6.5 - 7.1 (7.3) × (3.5) 3.8 - 4.5 (4.7) µm
Q = (1.4) 1.5 - 1.8 (1.9) ; N = 20
Me = 6.7 × 4.2 µm ; Qe = 1.6
Medidas ligeramente por encima de las anteriores.
Este mismo día y en un troco cercano al anterior, me encuentro con lo que parece tratarse de lo mismo:
La superficie poroide a 20 aumentos:
Hifas subiculares en solución de Rojo Congo:
Las hifas subiculares en Reactivo de Melzer:
Las mismas en solución de KOH:
En este estudio los basidiomas ya estaban bastante resecos y soltaron pocas esporas por medio de la esporulación natural, añado una imágen:
Aunque son pocas las esporas obtenidas, atendiendo a su morfología personalmente no me cabe duda de que en ambos estudios se trata de lo mismo.
Vamos con el árbol filogenético:
Aquí mi especie la "Antrodia JTP 2468/24", se encuentra perfectamente alineada dentro del Clado de lo que podemos considerar como Antrodia sinuosa = Amyloporia sinuosa = Adustoporia sinuosa.
La especie aquí descrita atendiendo a sus características, no se corresponde para nada con la descripción que hace Ryvarden de la Antrodia sinuosa en su trabajo de 2017, dejo la descripción de la especie:Antrodia sinuosa.
Sysr. Mycol. 1: 381, 1821.
"Basidiocarpos anuales, resupinados y a menudo ampliamente efusivos, ásperos y duros en seco, de hasta 3 mm de grosor, separables, raramente resinosos y abigarrados, margen blanco, fimbriado, estrecho o casi inexistente; superficie de los poros de color blanco marfil o madera o marrón sórdido pálido al secarse, poros angulares o sinuosos, de 1 a 3 (4) por mm, diseptimentos enteros a dentados, que al secarse suelen agrietarse y partirse en configuraciones semilaberínticas; subículo algodonoso-áspero, blanco, de aproximadamente 1 mm de grosor; capa tubular del mismo color que el subículo, de hasta 5 mm de grosor. Sistema hifal dimítico; hifas generativas fibuladas, de paredes gruesas, hialinas, de 2-4,5 μm de diámetro; hifas esqueléticas hialinas, de paredes gruesas o semisólidas, sinuosas a rectas, ocasionalmente ramificadas, de 2-5 μm de diámetro, más comunes en el subículo que en el tronco.
No hay cistidios, pero los cistidiolos fusoides no salientes suelen estar presentes entre los basidios, de 1,2-20 x 3-4 μm.
Basidios: de 11 a 15 x 4-5 μm, clavados.
Basidiosporas: de 4-6 (-7) x 1-2 μm, cilíndricas a subalantoides.
Sustratos: Madera muerta de coníferas como Abies, Larix, Picea y Pinus, a menudo sobre troncos quemados, y más raramente sobre maderas duras como Betula y Fraxinus.
Distribución: Común y circumpolar en la zona boreal de coníferas; en Europa, siguiendo a las coníferas dondequiera que crezcan de forma natural, o bien extendida en Norteamérica, Asia Oriental y el norte de África (Marruecos).
Observaciones: La especie suele ser fácil de reconocer en el campo debido a sus poros irregulares, a menudo con disepimentos dentados, y a su color marrón pálido sórdido al secarse."
De todo lo descrito solo encaja que según Ryvarden aparece a menudo sobre troncos quemados, no encajan los poros más pequeños y aunque angulares, ninguno agrietado y ni mucho menos semilaberíntico, y sobre todo no encajan para nada las medidas esporales según Ryvarden de 4-6 (-7) x 1-2 μm. y en mi estudio de (5.1) 5.2 - 5.7 (6) × (2.9) 3.3 - 3.8 (4) µm., unas medidas con una anchura estratosféricamente por encima.
Para poder comparar, añado unas imágenes correspondientes a 4 estudios míos anteriores realizados a lo que en su momento y atendiendo al criterio de Ryvarden, consideré como Antrodia sinuosa, todas recolectadas sobre madera de pino.
La primera imágen es de un estudio del 9 de noviembre de 2019:
En este estudio las esporas midieron:
(4.2) 4.6 - 5.5 (5.7) × (1.2) 1.4 - 1.65 (1.7) µm
Q = (2.7) 2.9 - 3.7 (4.2) ; N = 30
Me = 4.9 × 1.5 µm ; Qe = 3.3
Otra imágen esta es del 2 de abril de 2021:
Sus esporas con unas medidas de:
(4) 4.4 - 5.3 (6.1) × (1.2) 1.4 - 1.8 (2) µm
Q = (2.3) 2.6 - 3.4 (3.8) ; N = 40
Me = 4.9 × 1.6 µm ; Qe = 3
Seguimos con otro estudio realizado el 26 de mayo de 2024:
En este caso sus esporas arrojaron unas medidas de:
(4.3) 4.6 - 5.6 (6.2) × (1.4) 1.6 - 1.9 (2) µm
Q = (2.4) 2.7 - 3.3 (3.8) ; N = 27
Me = 5.1 × 1.8 µm ; Qe = 2.9
Y para terminar un estudio realizado el 15 de septiembre de 2024:
Sus esporas con unas medidas de:
(5) 5.2 - 5.7 (5.8) × (1.4) 1.44 - 1.7 (1.8) µm
Q = (3.1) 3.3 - 4 (4.1) ; N = 30
Me = 5.5 × 1.5 µm ; Qe = 3.6
En todos mis anteriores estudios, las medidas esporales encajan a la perfección con las indicadas por Ryvarden, así como los poros de mayor tamaño, con el borde dentado y hasta incluso laberínticos.
Conclusión: Si tal y como parece indicar en base a los datos moleculares debo aceptar que en este caso al igual que en mis estudios anteriores estamos ante la Antrodia sinuosa, la única explicación plausible, aunque Ryvarden no lo cita en su artículo, sería que lo que he considerado como esporas, no se trataría de basidiosporas sinó de clamidosporas, que procederían directamente de las hifas subhimeniales, no de los basidios, de todos modos tampoco me explico como estas aparentes clamidosporas, pueden presentar dos morfologías distintas.
No es la primera vez que me sucede algo parecido, cuatro años atrás y después de repetir por 2 veces el análisis molecular, sigo sin estar conforme con el resultado, dejo el enlace:
www.fungipedia.org/setas-informacion-y-c...or-buena.html#106963
A día de hoy sigo sin ver la Trametes versicolor por ningún lado, aunque el árbol filogenético no parece dejar lugar a dudas
Mi Trametes, la Trametes 1505137_32645_1B_ITS4B, queda perfectamente alineada dentro de lo que debemos considerar como Trametes versicolor.
Saludos.
Última Edición: 8 meses 4 semanas antes por Josep Torres. Razón: Cambiar una imágen
Por favor, Identificarse para unirse a la conversación.
- Foro
- Foros sobre Micología de fungipedia
- Microscopía
- Antrodia: Cuando los datos no se corresponden con la realidad.
Tiempo de carga de la página: 0.203 segundos

Foro de micología